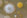
Microbiotiful Doudou 1

Select your Market
Various microorganisms can be found on a child’s Teddy. Do you recognize any of the ones we found on our contact plate?
Textile toys are there for children to cuddle, so it should come as no surprise that grime and dirt attaches to the fabric over time, an environment in which bacteria, molds, and yeasts can flourish. Disinfectant may kill them but it won’t remove the grime deposits, so the microbes be back in next to no time. There’s really only one way to keep a teddy hygienic, and that’s by washing, which is recommended about once a month. Check whether the one you plan to buy is washable and dries quickly. If unsure, test wash it immediately after purchase—before the child gets emotionally attached.